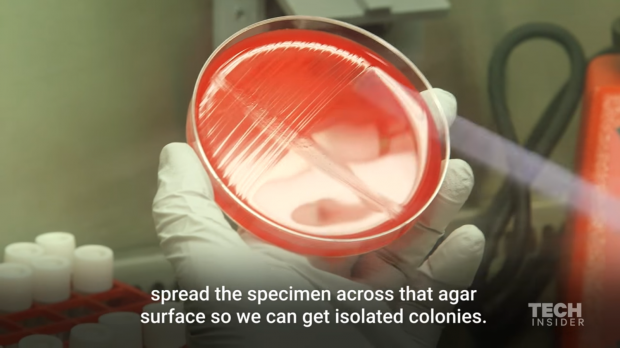
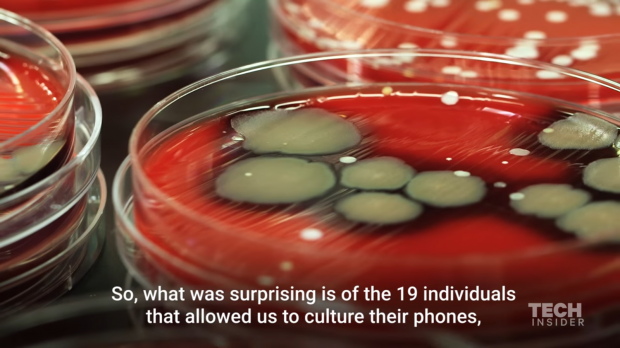
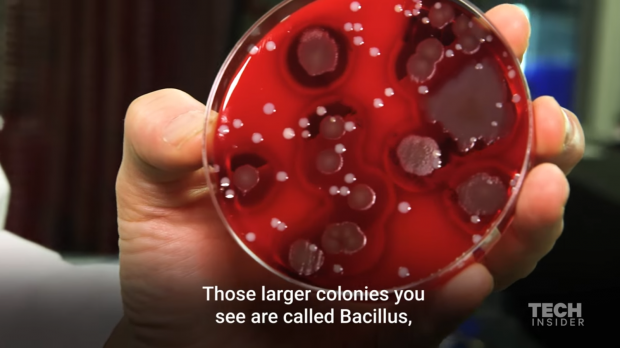

Với vẻ ngoài sang chảnh và đẹp đẽ, ít ai biết được rằng chiếc smartphone đang là nơi ẩn náu của hàng triệu triệu vi khuẩn gây hại cho sức khỏe.
Ngoài các tính năng giải trí như camera hay hỗ trợ xem video độ phân giải cao, smartphone ngày nay còn tích hợp thêm các công cụ làm việc hiệu quả và đó cũng chính là lý do tại sao nó trở thành vật bất ly thân của mỗi người. Tuy nhiên có thể bạn không biết rằng thiết bị mà bạn áp vào má mỗi ngày lại có đến hàng triệu triệu vi khuẩn đang ẩn náu. Để biết độ kinh dị của thế giới vi khuẩn này, bạn có thể xem video nghiên cứu được Techinsider thực hiện ngay dưới đây.
Nghiên cứu mới đây cho thấy, điện thoại di động là ổ vi khuẩn lớn nhất với lượng vi khuẩn gấp 20 lần so với bồn cấu vệ sinh mà chúng ta sử dụng hằng ngày. Mật độ phân bố vi khuẩn trên smartphone là 25.000 vi khuẩn/2.54 cm2, trong khi đó con số này trên bồn toilet chỉ là 1.201 vi khuẩn/2.54 cm2 (theo báo cáo của Mashables – kênh thông tin New York dựa trên nghiên cứu của Viện sử học vi sinh lâm sàng & kháng sinh tại Anh – Annals of Clinical Microbiology and Antimicrobials).
Con số nói trên có thể khiến nhiều người kinh ngạc nhưng ngẫm lại thì nó hoàn toàn hợp lý khi mà điện thoại thường xuyên được chuyền từ tay người này qua tay người khác, được đặt trên nhiều bề mặt hoặc nét vào túi xách hoặc túi quần trong nhiều điều kiện khác nhau. Nó có thể chứa vô số các vi khuẩn gây cảm cúm, đau mắt, ho,.. thậm chí là các vi khuẩn có mức độ nguy hại cao như E.coli và Staphylococcus aureus.
Tất nhiên là những vi khuẩn này có kích thước siêu nhỏ và mắt thường không thể nhìn thấy được, đó cũng chính là lý do tại sao hầu hết người dùng smartphone đều không mấy bận tâm đến việc vệ sinh chiếc dế yêu của mình. Cùng lắm là họ chỉ lau tạm vào quần áo hay một chiếc khăn vớ được từ một nơi nào đó không rõ.
Để người dùng nhận thức rõ hơn về vấn đề này, trang Techinsider đã đem các mẫu vi khuẩn thu thập được từ 19 chiếc điện thoại khác nhau đến phòng sinh học tế bào thuộc trường Đại học Columbia để kiểm nghiệm.
Đầu tiên là lấy mẫu vi khuẩn từ 19 chiếc điện thoại khác nhau. Phòng nghiên cứu đã lấy vi khuẩn từ mặt trước lẫn mặt sau của thiết bị nên tổng số mẫu vi khuẩn là 38 mẫu.
Để chuẩn bị môi trường lý tưởng cho vi khuẩn sinh sôi, Phó giáo sư Susan Whitter đã dùng thạch aga và phủ thêm 5% máu cừu (vốn là món ưa thích giúp vi khuẩn phát triển). Sau đó cho các mẫu vi khuẩn lên rồi đem ủ ở nhiệt độ 37 độ C để xem chúng phản ứng ra sao sau 24 và 48 giờ.
Và đây chính là dung nhan vi khuẩn ấn náu trên chiếc smartphone mà bạn sử dụng hằng ngày.
Có rất nhiều loại vi khuẩn nguy hiểm mà bạn không lường trước được.
Mẫu bên phải cho thấy điện thoại của người dùng này đã bị nhiễm vi khuẩn Staphylococcus aureus hay còn gọi là tụ cầu khuẩn. Trong đa số trường hợp, tụ cầu khuẩn không gây ra vấn đề gì nghiêm trọng mà chỉ gây nhiễm khuẩn nhẹ như nổi mụn hoặc bóng nước. Nhưng trong một số trường hợp, tụ cầu khuẩn có thể gây nhiễm khuẩn trầm trọng hơn.
Còn mẫu bên trái thì bị nhiễm khuẩn MRSA, và sẽ rất dễ gây nhiễm trùng nếu tiếp xúc vào vết thương của người dùng.
Theo con số thống kê từ 19 người tham gia thử nghiệm này thì có đến 75% trong số họ thừa nhận sử dụng điện thoại trong nhà trắm. Hai trong số 75% này dương tính với khuẩn Fecal xuất phát từ phân.
Trong 38 mẫu thử thì có đến 34 mẫu bị nhiễm khuẩn.
17 trong số đó bị nhiễm khuẩn que.
4 mẫu bị nhiễm khuẩn E. coli và Klebsiella Pneumoniae.
Hy vọng sau khi đọc được kết quả nghiên cứu này, bạn sẽ cẩn thận hơn khi sử dụng điện thoại cũng như có những cách vệ sinh smartphone hiệu quả để phòng tránh nguy cơ nhiễm bệnh không mong muốn.
Ho Huyn
Nguồn: Techinsider
Nguồn: fptshop.com.vn